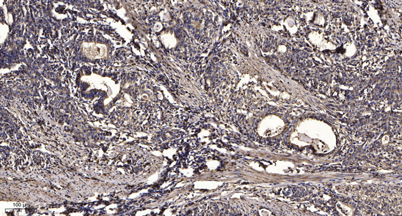

CYP3A4/5 rabbit pAb
 One-click to copy product information
One-click to copy product information$148.00/50µL $248.00/100µL
| 50 µL | $148.00 |
| 100 µL | $248.00 |
Overview
| Product name: | CYP3A4/5 rabbit pAb |
| Reactivity: | Human;Rat;Mouse; |
| Alternative Names: | CYP3A4; CYP3A3; Cytochrome P450 3A4; 1; 8-cineole 2-exo-monooxygenase; Albendazole monooxygenase; Albendazole sulfoxidase; CYPIIIA3; CYPIIIA4; Cytochrome P450 3A3; Cytochrome P450 HLp; Cytochrome P450 NF-25; Cytochrome P450-PCN1; Nifedipine |
| Source: | Rabbit |
| Dilutions: | Western Blot: 1/500 - 1/2000. Immunohistochemistry: 1/100 - 1/300. Immunofluorescence: 1/200 - 1/1000. ELISA: 1/10000. Not yet tested in other applications. |
| Immunogen: | The antiserum was produced against synthesized peptide derived from human Cytochrome P450 3A4/5. AA range:251-300 |
| Storage: | -20°C/1 year |
| Clonality: | Polyclonal |
| Isotype: | IgG |
| Concentration: | 1 mg/ml |
| Observed Band: | 57kD |
| GeneID: | 1576/1577 |
| Human Swiss-Prot No: | P08684/P20815 |
| Cellular localization: | Endoplasmic reticulum membrane; Single-pass membrane protein. Microsome membrane ; Single-pass membrane protein. |
| Background: | This gene encodes a member of the cytochrome P450 superfamily of enzymes. The cytochrome P450 proteins are monooxygenases that catalyze many reactions involved in drug metabolism and synthesis of cholesterol, steroids and other lipids. This protein localizes to the endoplasmic reticulum and its expression is induced by glucocorticoids and some pharmacological agents. This enzyme is involved in the metabolism of approximately half the drugs in use today, including acetaminophen, codeine, cyclosporin A, diazepam and erythromycin. The enzyme also metabolizes some steroids and carcinogens. This gene is part of a cluster of cytochrome P450 genes on chromosome 7q21.1. Previously another CYP3A gene, CYP3A3, was thought to exist; however, it is now thought that this sequence represents a transcript variant of CYP3A4. Alternatively spliced transcript variants encoding different isofor |
-
 Western Blot analysis of Jurkat cells using CYP3A4/5 Polyclonal Antibody
Western Blot analysis of Jurkat cells using CYP3A4/5 Polyclonal Antibody -
 Western blot analysis of lysates from Jurkat cells, using Cytochrome P450 3A4/5 Antibody. The lane on the right is blocked with the synthesized peptide.
Western blot analysis of lysates from Jurkat cells, using Cytochrome P450 3A4/5 Antibody. The lane on the right is blocked with the synthesized peptide. -
Immunohistochemical analysis of paraffin-embedded human Gastric adenocarcinoma. 1, Antibody was diluted at 1:200(4° overnight). 2, Tris-EDTA,pH9.0 was used for antigen retrieval. 3,Secondary antibody was diluted at 1:200(room temperature, 45min).
Immunohistochemical analysis of paraffin-embedded human Gastric adenocarcinoma. 1, Antibody was diluted at 1:200(4° overnight). 2, Tris-EDTA,pH9.0 was used for antigen retrieval. 3,Secondary antibody was diluted at 1:200(room temperature, 45min).

 Manual
Manual